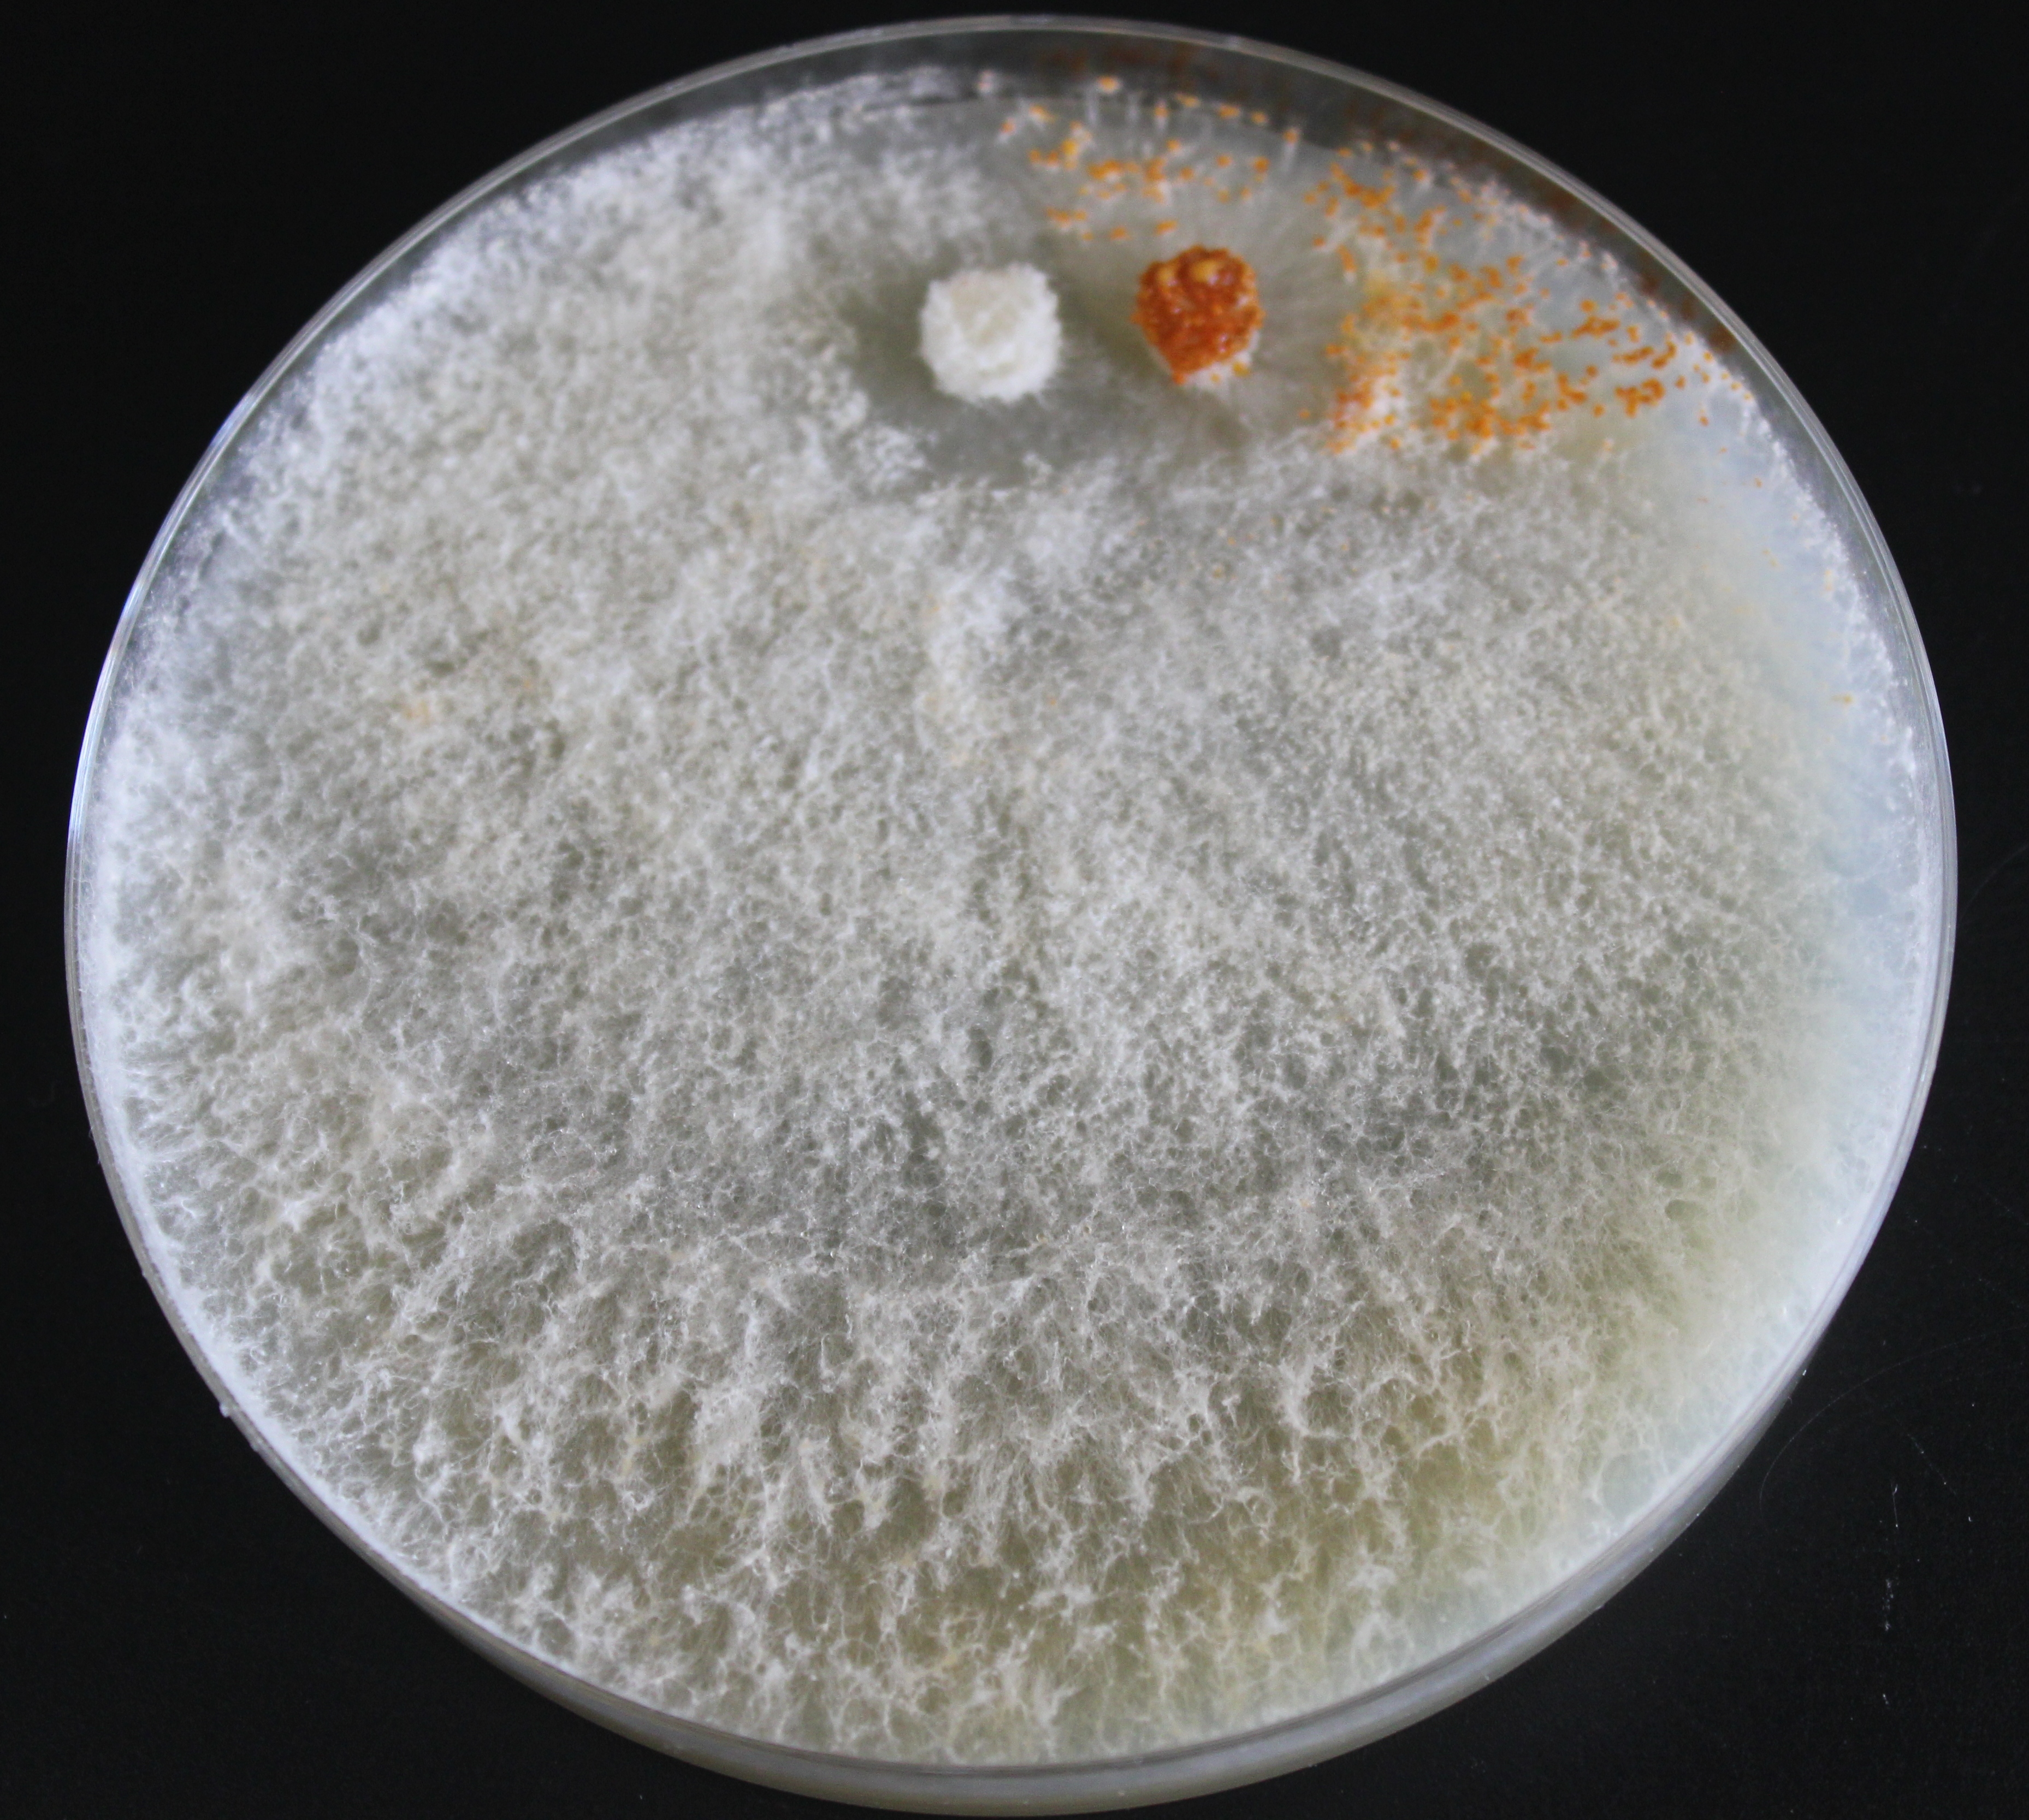
Cepa virulenta de Cryphonectria parasitica (color naranja) que al ser infectada por el hipovirus se está transformando en hipovirulenta.

Microbianos
-
Colección de bacterias y hongos del Programa de Patología Vegetal
El programa de Patología Vegetal conserva una colección de cultivos que incluye tanto bacterias como hongos de potencial relevancia en el campo de las enfermedades que afectan a cultivos y a masas forestales. Se nutre de las cepas obtenidas en diversos proyectos de investigación realizados, así como trabajos encomendados en el tiempo que lleva funcionando el laboratorio. Respecto a las bacterias, hay alrededor de 3.000 cepas conservadas, y 1.100 de ellas en colección activa.
Cepa virulenta de Cryphonectria parasitica (color naranja) que al ser infectada por el hipovirus se está transformando en hipovirulenta.
-
Colección de recursos genéticos microbianos de origen sidrero.
El SERIDA conserva, desde los años 80, recursos genéticos microbianos responsables de procesos fermentativos en la colección denominada CCAS (Colección de Cultivos Autóctonos del SERIDA). La mayoría de esos recursos son representativos de las zonas geográficas con mayor producción de sidra de Asturias y proceden de diferentes tipos de alteraciones en esta bebida, aunque también recientemente el SERIDA ha empezado a preservar cepas de mieles que han sufrido un proceso de fermentación espontánea.
Los proyectos de investigación que se han ido llevando a cabo desde que se inició la colección han permitido elaborar un catálogo, de uso interno para el Área de Tecnología de los Alimentos,que permite gestionar la información disponible de un 70% de estos recursos.
La CCAS es una colección en continua expansión que alberga en la actualidad aproximadamente unos 3.000 recursos aislados y ha permitido, desde sus orígenes, salvaguardar la diversidad de recursos genéticos microbianos de origen sidrero, así como disponer de material genético para realizar investigaciones con el objetivo de ofrecer una mayor variedad y calidad de productos relacionados con la manzana y la sidra en Asturias.
La CCAS está adherida a REDESMI (Red Española de Microorganismos) desde el año 2015, con el fin de poner en valor los cultivos
microbianos de la sidra y las mieles, y ampliar el conocimiento y difusión de este tipo de recursos.

Imágenes de cultivos puros de levaduras y bacterias lácticas de la CCAS.
- Patógenos Animales